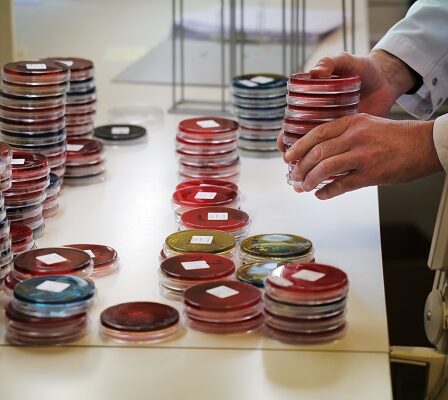
La Norvège enregistre de nouveaux cas de chiens souffrant de diarrhée sanglante 11 La Norvège enregistre de nouveaux cas de chiens souffrant de diarrhée sanglante - 10

L’article continue sous l’annonce Dans une récente analyse de l’aviation en Europe, le responsable de l’analyse Jacob Pedersen à la …
souffrant
L’année dernière, le district de police de l’Ouest a eu plus de 4 000 affectations liées à des personnes souffrant de troubles mentaux
Photo : Marit Hommedal / NTB Au cours des cinq dernières années, le district de police de l’Ouest a quintuplé …
Ouverture d’un dossier d’inspection contre Bergen après l’admission à l’hôpital d’un garçon souffrant de malnutrition
Photo : Marianne Løvland / NTB Le gouverneur du comté de Vestland ouvre un dossier d’inspection contre la municipalité de …
La Norvège enregistre de nouveaux cas de chiens souffrant de diarrhée sanglante
Analyses d’échantillons de chiens.Photo : Ørn E. Borgen / NTB scanpix Plusieurs nouveaux cas de diarrhée sanglante ont été détectés …
Un prêtre a rencontré plusieurs étudiants souffrant d’anxiété climatique
Une jeune fille tient un globe alors qu’elle participe à une manifestation à Mumbai, en Inde, le vendredi 27 septembre …
Les jeunes souffrant de troubles de l’alimentation dénoncent l’abus d’alimentation
Les jeunes souffrant de troubles de l’alimentation décrivent l’alimentation forcée comme un abus De nombreux patients norvégiens se sentent maltraités …